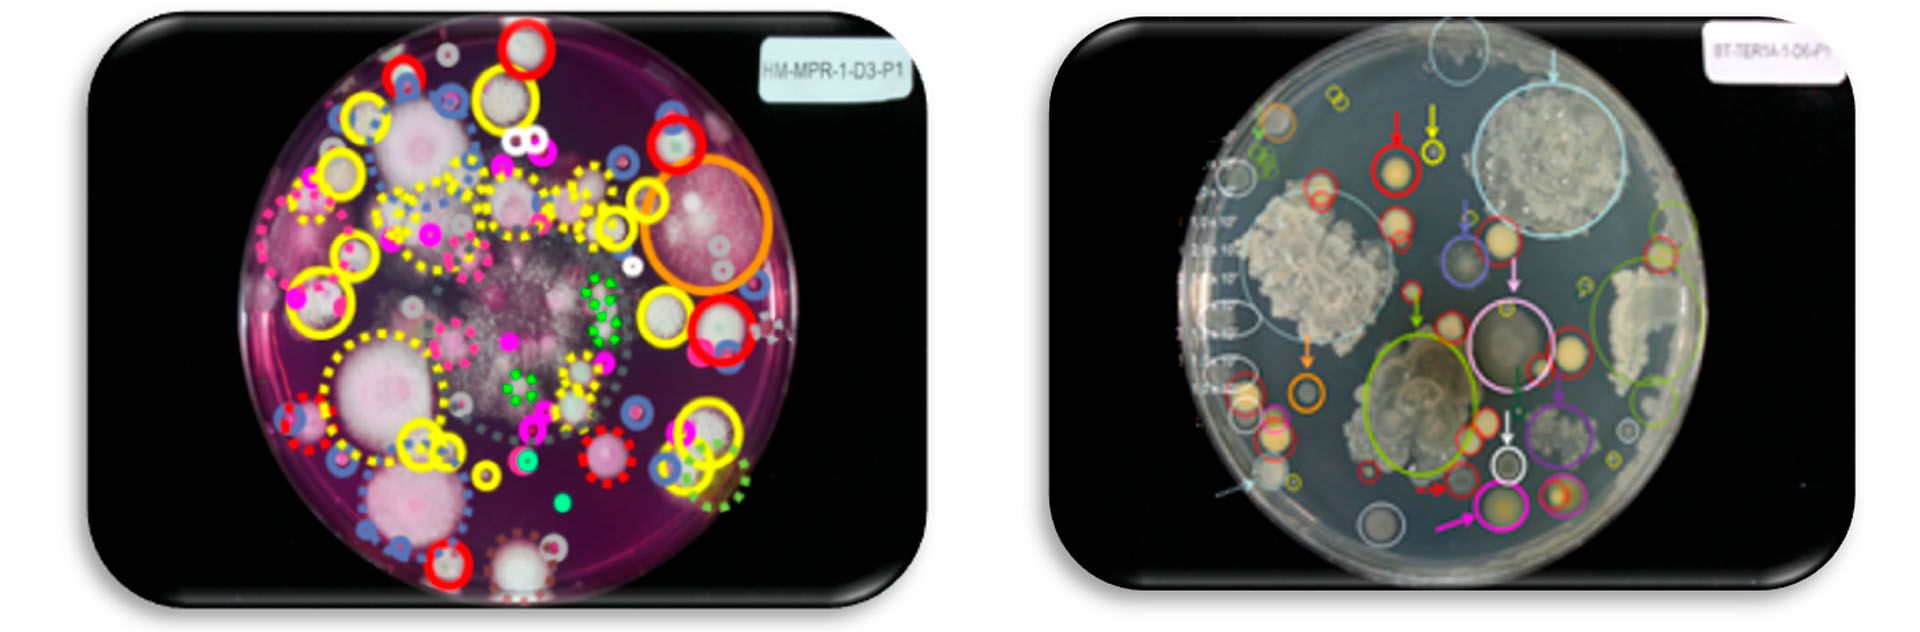
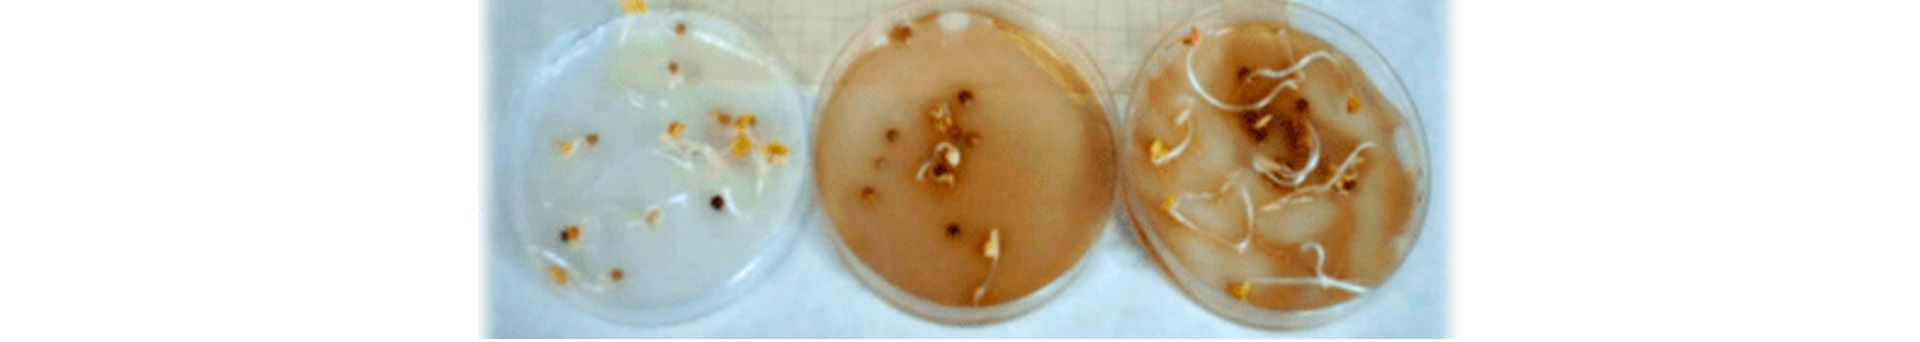

26 September 2025
Autores: Francisca Suárez Estrella; María José Estrella González; María José López López; Víctor Carpena-Istan; María Valverde Carpintero; Alicia Mª González Céspedes.
El sector agrícola intensivo genera gran cantidad de volúmenes de residuos vegetales que, sin una gestión adecuada, plantean problemas ambientales y fitosanitarios. Sin embargo, estos residuos poseen propiedades valiosas que pueden ser aprovechadas a través de la valorización, especialmente mediante el proceso de compostaje.
Este proceso, definido como una "biotransformación aerobia de la materia orgánica en un producto de alto valor agronómico llamado compost" (Moreno y Mormeneo, 2011), se alinea con el concepto de economía circular, buscando "que el residuo tenga un uso útil, sustituyendo a otros materiales que de otro modo se habrían utilizado" (Ley 7/2022 del 8 de abril).
El compostaje es un proceso dinámico con diferentes etapas térmicas (mesófila, termófila, enfriamiento y maduración) y una compleja sucesión de poblaciones microbianas (bacterias, actinomicetos, hongos y arqueobacterias). Su optimización depende del control de parámetros clave como aireación, humedad, temperatura, pH, materia orgánica, relación C/N, conductividad eléctrica y metales pesados.
Producción de lixiviados de compostaje
A pesar de las ventajas que supone el compostaje, presenta problemas ambientales, como la formación de efluentes líquidos y olores por exceso de humedad y desequilibrios de nutrientes. Estos lixiviados, al descomponerse, pueden liberar contaminantes biodisponibles, que deben ser tratados adecuadamente antes de su eliminación o uso agrícola para evitar efectos adversos en el medio ambiente. (Roy et al., 2018).
- Los lixiviados del compostaje pueden proceder de:
- El contenido de agua de los propios residuos orgánicos,
- el agua generada durante las reacciones bioquímicas del compostaje,
- el agua de lluvia (instalaciones abiertas) y
- el agua añadida para ajustar el contenido de humedad (Roy et al., 2018).
Su producción está relacionada con la tecnología de compostaje, el tipo de residuos compostados y las condiciones climáticas.
Los residuos orgánicos, como los restos vegetales son una fuente importante de materia orgánica biodegradable, metales pesados y contaminantes emergentes. La presencia de un alto contenido de materia orgánica en los lixiviados es el resultado de la descomposición de materia orgánica compleja en sustancias más simples por diversos microorganismos en condiciones aeróbicas. Inicialmente, los microorganismos ya presentes en la fase líquida utilizan la materia orgánica biodegradable disuelta fácilmente disponible. Los microorganismos producen simultáneamente enzimas que reaccionan con la materia orgánica sólida para liberar moléculas solubles y fácilmente disponibles. La materia orgánica e inorgánica puede transferirse a la fase líquida a través de la transferencia de masa sólido-líquido.
Los lixiviados de compost a menudo se tratan como aguas residuales y muy pocos estudios han caracterizado el uso de estos lixiviados de compost para aplicaciones agrícolas debido a la variación del rango de nutrientes, los contaminantes potenciales y la necesidad de un tratamiento previo antes de su uso.
En este trabajo se va a exponer algunos de los resultados obtenidos dentro del proyecto LIXAGRO (Bioeconomía circular de los restos de cultivo para su reutilización en agricultura, GOPG-AL-23-0005), donde se evaluó el potencial biofertilizante de muestras de compost y de lixiviados de compostaje. Para ello, se plantearon los siguientes objetivos específicos:
- Caracterización fisicoquímica y microbiológica de compost y lixiviados.
- Evaluación del carácter fitotóxico del compost y lixiviados.
Metodología
Se realizó un ensayo de compostaje a escala piloto en las instalaciones de la Estación Experimental Cajamar en 'Las Palmerillas' (El Ejido, Almería), utilizando cinco pilas de residuos vegetales procedentes de agricultura intensiva, cada una con un peso de 450 Kg y un volumen de 800 L.
En etapas anteriores del proyecto LIXAGRO se identificaron y seleccionaron 3 cepas del género Pseudomonas spp. (GL1, GL3 y GL5), que mostraron actividad ligninasa, celulasa y quitinasa in vitro, por lo que se consideraron buenas candidatas para ser aplicadas en ensayos de bioaumentación de compost y lixiviados.
El material de partida, suministrado por la empresa SACh (Servicios Ambientales Las Chozas SL), fue humedecido hasta alcanzar una humedad cercana al 60 % utilizando agua o lixiviado estabilizado de la misma empresa. Se establecieron los siguientes cinco tratamientos utilizando las 3 bacterias seleccionadas en consorcio para aplicarse en el proceso de compostaje en los tratamientos considerados. Los tratamientos fueron:
- Tratamiento C1: Pila Control, humectada exclusivamente con agua.
- Tratamiento C2: Pila humectada con lixiviado estabilizado.
- Tratamiento C3: Pila inoculada con un consorcio bacteriano a una concentración de 10^5 UFC (de cada cepa) por gramo de residuo.
- Tratamiento C4: Pila inoculada con el consorcio bacteriano (10^5 UFC/g de residuo) junto con lixiviado estabilizado.
- Tratamiento C5: Pila inoculada con el consorcio bacteriano (10^5 UFC/g de residuo) junto con lixiviado estabilizado, y adicionalmente se le añadió flutriafol (Impact®), propamocarb y fosetil (Previcur®).

Los lixiviados de las cinco pilas se recogían independientemente y se utilizaban para el riego de la pila hasta el primer volteo. Después de un mes, la recogida de lixiviados y la humectación se realizaron semanalmente hasta el segundo volteo, momento en que se inició la fase de enfriamiento y maduración. Las muestras de compost y lixiviados se recogieron y analizaron en las fases clave del proceso: materia prima (MPR), termófila (TER), enfriamiento (ENF) y maduración (MAD).
Se determinaron las siguientes medidas:
- Caracterización Fisicoquímica: se analizaron pH, conductividad eléctrica, humedad (solo compost), materia orgánica, cenizas, relación C/N y compuestos fenólicos.
- Caracterización Microbiológica: se cuantificaron grupos microbianos generales (bacterias mesófilas, hongos mesófilos, actinobacterias), grupos con potencial biofertilizante (solubilizadores de fosfato, potasio, calcio y productores de sideróforos) y grupos degradadores de lignocelulosa (xilanolíticos, celulolíticos, ligninolíticos).
- Evaluación del Efecto Fitotóxico (in vitro): se realizaron bioensayos de germinación en semillas de berro (Lepidium sativum) con diluciones de compost (1/10), lixiviados (1:5, 1:10, 1:25, 1:50) y extractos acuosos de compost (1:5). Se calculó el Índice de Germinación (IG).
Resultados y discusión
1.- Caracterización fisicoquímica del compost
La caracterización fisicoquímica del compost se realizó analizando parámetros clave que indican la calidad y madurez del producto final. La normativa española vigente establece que el compost debe cumplir con propiedades como un mínimo del 40 % de materia orgánica, un máximo del 40 % de humedad y una relación C/N inferior a 15.
En la Tabla 1 se muestran los resultados derivados del análisis de parámetros fisicoquímicos en las muestras de compost.
- Materia Orgánica (MO): el porcentaje de materia orgánica disminuyó en todas las pilas a lo largo del proceso de compostaje, lo cual es un indicativo de la actividad de degradación microbiana. Las pilas C3 y C4, inoculadas con el consorcio microbiano, mostraron una disminución particularmente notable de la MO (Tabla 1).
En la fase de maduración, la pila C4 (inoculada con el consorcio y lixiviado maduro) alcanzó el valor más bajo de MO (43,34 %), significativamente inferior al resto de las pilas (Tabla 1).
Este hallazgo es consistente con estudios previos (Jurado et al., 2015) que observaron una mayor degradación de la materia orgánica en pilas inoculadas con microorganismos especializados en descomponer moléculas complejas como la lignina, celulosa y hemicelulosa. A pesar de la disminución, todas las pilas cumplieron con el requisito legal de tener un valor de MO superior al 40 % en el producto final, coincidiendo con lo obtenido por López-González et al. (2015b).
- Cenizas: el porcentaje de cenizas mostró un comportamiento inverso al de la materia orgánica, aumentando a medida que la MO disminuía. Al final del compostaje, el contenido de cenizas más bajo se observó en las pilas C2 y C5, mientras que los valores más altos se encontraron en C3 y C4 (Tabla 1). Esto se relaciona directamente con la mayor o menor degradación de la materia orgánica en las pilas.
- Compuestos fenólicos: el nivel de compuestos fenólicos es un indicador de la calidad y madurez del compost: niveles bajos sugieren madurez, mientras que concentraciones altas indican inestabilidad. Se observó una tendencia general decreciente en los compuestos fenólicos a lo largo del proceso, lo que es un buen indicador de estabilización, en línea con otros estudios (López-González et al., 2013; Jurado et al., 2015).
En la fase de maduración, la pila C5 alcanzó el nivel más bajo (1,39 g/100 g MS), lo que sugiere un alto grado de estabilización en esta pila. Estos valores son similares a los obtenidos en compost de residuos vegetales por Estrella-González et al. (2020).
- Relación C/N (carbono/nitrógeno): la relación C/N es un indicador crucial de la madurez del compost. Al inicio del proceso (fase MPR), los valores de C/N en las pilas oscilaron entre 10,35 (C4) y 14,74 (C2), lo que se considera por debajo del rango óptimo recomendado (25-35) para el inicio del compostaje. Sin embargo, en la fase de maduración, todas las pilas mostraron valores entre 8,87 y 9,90, cumpliendo con el límite establecido por el Real Decreto 529/2023.
Las pilas inoculadas con el consorcio (C3, C4 y C5) presentaron una relación C/N más baja desde el inicio (MPR) en comparación con C1 y C2. Esto sugiere que el inóculo bacteriano tuvo un efecto temprano, acelerando la transformación de compuestos orgánicos fácilmente degradables.
2.- Caracterización Microbiológica del Compost y Lixiviados
Se evaluaron los diferentes grupos microbianos que contenía tanto los compost como los lixiviados a lo largo de las fases del compostaje.
- Bacterias Aerobias Totales: los recuentos las bacterias aerobias totales en el compost variaron generalmente entre 6 y 9 unidades logarítmicas (Figura 3A). La pila C4 mostró los recuentos más altos en todas las fases, llegando a casi 10 unidades logarítmicas en la fase inicial (MPR).
En la fase de maduración (MAD), se observó una estabilización de los recuentos microbianos en torno a 8 log UFC/g en todas las pilas, lo cual concuerda con estudios previos (López-González et al., 2013), quienes estudiaron la dinámica de la microbiota durante las etapas del compostaje de residuos lignocelulósicos y observaron que las bacterias mesófilas alcanzaron su valor máximo en MPR (9 log UFC/g), seguido de una disminución hasta 7 unidades logarítmicas en la etapa de maduración.
La pila C4 presentó el recuento medio más elevado, destacándose en el grupo de homogeneidad más alto. Esto se atribuye al efecto combinado del consorcio microbiano y el lixiviado maduro aplicado a esta pila.
En los lixiviados (Figura 3B), los recuentos fueron inferiores a los del compost, promediando alrededor de 7 unidades logarítmicas en etapas intermedias y cercanas a 6 log UFC/mL en maduración.
De manera general, los mayores recuentos se obtuvieron en las pilas inoculadas con el consorcio (C3, C4 y C5). Esta tendencia coincide con lo descrito por Jurado et al. (2015), quienes observaron mayores recuentos microbianos y un aumento de la actividad enzimática en pilas inoculadas con un consorcio microbiano durante el compostaje de restos agrícolas, lo que produjo una mayor descomposición de las fracciones orgánicas poliméricas y, por consiguiente, una mayor disponibilidad de compuestos solubles simples.

- Microorganismos ligninolíticos: en las muestras de compost la actividad de la microbiota ligninolítica se mantuvo entre 6 y 8 log UFC/g en todas las fases (Figura 4A). Se observó una actividad notable de estos microorganismos principalmente en las etapas finales (ENF y MAD), lo cual coincide con los hallazgos de Jurado et al., (2015).
Para los lixiviados (Figura 4B), los recuentos fueron significativamente más bajos que en el compost, alcanzando valores promedio de alrededor de 5 log UFC/mL en la fase de maduración.
La pila C4 también mostró los recuentos más elevados en los lixiviados para este grupo. La menor abundancia de microbiota ligninolítica en el lixiviado se explica por el hecho de que la lignina es un polímero insoluble que se encuentra principalmente en la fracción sólida del compost, limitando la proliferación de estos microorganismos en el medio líquido.

- Pseudomonas spp.: en las muestras de compost los recuentos de Pseudomonas spp. mostraron una tendencia ascendente a lo largo del proceso, con valores superiores en las fases de enfriamiento y maduración (Figura 5A). Esto se debe a que en las primeras fases (MPR y TER) hay una mayor diversidad microbiana y competencia por el sustrato, mientras que la fase de enfriamiento es térmicamente más estable, lo que favorece la adaptación de estos microorganismos.
En contraste, en los lixiviados (Figura 5B) se observó un mayor crecimiento en la fase inicial y de enfriamiento. Esta diferencia podría deberse a la movilidad y adaptación de Pseudomonas spp. en medios líquidos. Estudios sugieren que el agua lixiviada actúa como vehículo para el arrastre y concentración de estos microorganismos desde los residuos sólidos (Nugrahapraja et al., 2022) provocando que se concentre en los lixiviados. Las pilas inoculadas (C3, C4, C5) y sus lixiviados (L3, L4, L5) se agruparon en los grupos de homogeneidad superiores respecto al recuento de Pseudomonas spp.

- Bacterias solubilizadoras de fosfato: respecto a la microbiota solubilizadora de fosfato (Figura 6A), los valores oscilaron entre 5,13 y 7,55 en la etapa de maduración en las muestras de compost. Al igual que lo observado por López-González et al. (2015a), su actividad fue mayor en la etapa mesófila y su abundancia en la comunidad bacteriana disminuyó a medida que avanzaba el compostaje. La Figura 6A, muestra valores significativamente superiores de este grupo microbiano en las pilas C3 y C4, ambas inoculadas con el consorcio.
A pesar de Pseudomonas spp. es uno de los géneros bacterianos solubilizadores de fosfato más potentes (Behera et al., 2014). Por ello, este incremento podría deberse a un efecto indirecto del consorcio sobre la microbiota autóctona, favoreciendo el desarrollo o la actividad de microorganismos solubilizadores de fosfato ya presentes en el compost. Sin embargo, en los lixiviados (Figura 6B), los recuentos fueron menores, en torno a 5 unidades logarítmicas en todas las pilas.

- Bacterias Productoras de Sideróforos: en el compost los recuentos de microorganismos productores de sideróforos (moléculas quelantes de hierro) variaron entre 2,30 y 7,84 log UFC/g. En la fase de maduración, el promedio fue de 4,73 unidades logarítmicas (Figura 7A).
En los lixiviados (Figura 7B), los valores estuvieron entre 1,10 y 2,86 log UFC/mL, con un promedio de 1,25 unidades logarítmicas en maduración. Estos resultados son similares a los obtenidos por Vílchez-Sánchez (2024), obtuvo resultados similares analizando productos finales derivados del compostaje de restos vegetales.
La pila C3 mostró el mayor crecimiento de este grupo, lo cual se atribuye a la presencia del consorcio microbiano, ya que varias especies de Pseudomonas son conocidas por su capacidad de producir sideróforos. Un estudio de Suárez-Estrella et al. (2019) aisló Pseudomonas putida de compost con capacidad para producir sideróforos y controlar fitopatógenos.

3.- Estudio de Fitotoxicidad en Compost y Lixiviados
La madurez de un compost se relaciona con el grado de transformación de la materia orgánica durante el proceso de compostaje, así como con la potencial de fitotoxicidad del producto final. La evaluación de la fitotoxicidad está estrechamente relacionada con la estabilidad biológica, ya que la actividad microbiana presente en un material orgánico inestable puede derivar en la generación de compuestos fitotóxicos (Cesaro et al., 2019). Si el proceso de compostaje se realiza correctamente, la fitotoxicidad de los materiales irá en descenso, llegando incluso a conseguir que el compost final tenga un marcado carácter fitoestimulante.
El Índice de Germinación (IG) es un parámetro clave para evaluar la calidad final del compost. Los materiales con valores de IG inferiores al 50 % son altamente fitotóxicos, entre el 50 % y el 80 % son moderadamente fitotóxicos, entre 80 % y 100 % no son fitotóxicos, y superiores al 100 % se consideran potencialmente fitoestimulantes.
La Figura 9 muestra los Índices de Germinación derivados de las muestras de compost y lixiviados. Las pilas C3, C4 y C5 mostraron un efecto fitoestimulante con valores superiores al 150 %, mientras que las pilas C1 y C2 mostraron valores entre 90 % y 110 %.
Este comportamiento puede explicarse por la capacidad promotora del crecimiento vegetal que presentan muchas cepas de Pseudomonas. Según Suárez-Estrella et al. (2019), numerosas cepas de Pseudomonas, entre ellas P. putida, han demostrado estimular la germinación de semillas y favorecer el desarrollo de brotes y raíces en distintos cultivos, como garbanzo y soja. Este efecto se debe a una acción sinérgica que incluye la producción de fitohormonas, sideróforos, la mejora de la disponibilidad de nutrientes y la supresión de patógenos.
Por lo tanto, la inoculación del consorcio podría haber contribuido no solo a la eliminación de compuestos fitotóxicos residuales, sino también a mejorar el entorno de germinación. Al igual que lo obtenido por Estrella-González et al., (2020), el mejor valor de IG (181,58 %) obtenido en la pila C5 coincidió con el promedio más bajo de compuestos fenólicos, mostrando el grupo de homogeneidad más alto.

Con el objetivo de reducir la fitotoxicidad del lixiviado se hicieron diluciones 1:50. Aunque en estudios previos, como el de Vílchez-Sánchez (2024) con compost y lixiviados procedente de restos vegetales, la dilución 1:50 fue eficaz para evitar efectos fitotóxicos, los resultados obtenidos en este trabajo mostraron valores de Índice de Germinación (IG) en los lixiviados comprendidos entre el 50 % y el 70 %, lo que corresponde a fitotoxicidad moderada, sin mostrar diferencias significativas entre las distintas pilas.
Esto podría deberse a que, aunque estos lixiviados fueron recogidos durante la etapa de maduración, puede que aún no sean los suficientemente estables. A diferencia del lixiviado maduro, aireado y estabilizados en balsas, estos lixiviados se recogieron directamente de las pilas, por lo que podrían necesitar un proceso de estabilización más prolongado para reducir la presencia de compuestos fitotóxicos.
Además de la estabilidad, diversos estudios han demostrado que la dilución del lixiviado debe ajustarse tanto a los requerimientos nutricionales del cultivo como a la composición química del lixiviado, con el objetivo de garantizar su eficacia sin comprometer la salud del suelo ni inducir efectos fitotóxicos (Ahamad-Sanadi et al., 2021). En conjunto, los resultados obtenidos evidenciaron que la aplicación del consorcio formado por GL1, GL3 y GL5, mejoró notablemente la calidad microbiológica y agronómica del compost y de los lixiviados.
Conclusiones
Los resultados obtenidos en este estudio demostraron que la aplicación del consorcio microbiano formado por GL1, GL3 y GL5 mejoró significativamente la calidad microbiológica y agronómica del compost y, en menor medida, de los lixiviados.
El consorcio promovió una mayor degradación de la materia orgánica, una maduración más rápida (evidenciada por la relación C/N y los compuestos fenólicos) y, lo más notable, un marcado efecto fitoestimulante en el compost de las pilas inoculadas. Aunque los lixiviados de maduración mostraron una fitotoxicidad moderada incluso diluidos, se sugiere una mayor estabilización para su uso seguro.
Agradecimientos
El proyecto ha sido financiado por un Proyecto Operativo de la Asociación Europea de Innovación (AEI) en materia de productividad y sostenibilidad agrícolas, titulado “Bioeconomía circular de los restos de cultivo para su reutilización en agricultura (GO-LIXAGRO, GOPG-AL-23-0005)”, liderado por Coexphal en colaboración con la Fundación Grupo Cajamar, la Universidad de Almería y Servicios Ambientales Las Chozas (SACH).

Bibliografía
- Ahamad Sanadi, N F.B., Ibrahim, N., Ong, P.y., Klemeš, J.J., Li, C., & Lee, C.T. (2021). Dilution rate of compost leachate from different biowaste for the fertigation of vegetables. Journal of Environmental Management, 295(113010), 113010. https://doi.org/10.1016/j.jenvman.2021.113010
- Cesaro, A., Conte, A., Belgiorno, V., Siciliano, A., & Guida, M. (2019). The evolution of compost stability and maturity during the full-scale treatment of the organic fraction of municipal solid waste. Journal of Environmental Management, 232, 264–270. https://doi.org/10.1016/j.jenvman.2018.10.121
- Estrella-González, M. J., Suárez-Estrella, F., Jurado, M. M., López, M. J., López-González, J. A., Siles-Castellano, A. B., Muñoz-Mérida, A., & Moreno, J. (2020). Uncovering new indicators to predict stability, maturity and biodiversity of compost on an industrial scale. Bioresource Technology, 313(123557), 123557. https://doi.org/10.1016/j.biortech.2020.123557
- Jurado, M. M., Suárez-Estrella, F., López, M. J., Vargas-García, M. C., López-González, J. A., & Moreno, J. (2015). Enhanced turnover of organic matter fractions by microbial stimulation during lignocellulosic waste composting. Bioresource Technology, 186, 15–24. https://doi.org/10.1016/j.biortech.2015.03.059
- López-González, J. A., Suárez-Estrella, F., Vargas-García, M. C., López, M. J., Jurado, M. M., & Moreno, J. (2015a). Dynamics of bacterial microbiota during lignocellulosic waste composting: Studies upon its structure, functionality and biodiversity. Bioresource Technology, 175, 406-416. https://doi.org/10.1016/j.biortech.2014.10.123
- López-González, J. A., Vargas-García, M. C., López, M. J., Suárez-Estrella, F., Jurado, M. M., & Moreno, J. (2015b). Biodiversity and succession of mycobiota associated to agricultural lignocellulosic waste-based composting. Bioresource Technology, 187, 305–313. https://doi.org/10.1016/j.biortech.2015.03.124
- López-González, J. A., López, M. J., Vargas-García, M. C., Suárez-Estrella, F., Jurado, M., & Moreno, J. (2013). Tracking organic matter and microbiota dynamics during the stages of lignocellulosic waste composting. Bioresource Technology, 146, 574–584. https://doi.org/10.1016/j.biortech.2013.07.122.
- Moreno, J., & Mormeneo, S. (2011). Microbiología y bioquímica del proceso de compostaje. En: Compostaje (Moreno, J. y Moral, R., Eds), pp. 111-140. Ediciones Mundi-Prensa, Madrid.
- Nugrahapraja, H., Zia, J. K., & Permana, A. D. (2022). Response of microbial community structure and dynamics of Black Soldier Fly organic waste treatment using omics technology approach. Report Grant Research, Asahi Glass Foundation.
- Roy, D., Azaïs, A., Benkaraache, S., Drogui, P., & Tyagi, R. D. (2018). Composting leachate: characterization, treatment, and future perspectives. Reviews in Environmental Science and Bio/Technology, 17, 323-349.
- Salamanca, M. Y. L., & Cohecha, E. Á. (2014). Uso en horticultura de los desechos orgánicos de la planta de tratamiento de Villanueva, Casanare, Colombia. Revista Sistemas de Producción Agroecológicos, 5(2), 143-159.
- Suárez-Estrella, F., Jurado, M. M., López, M. J., López-González, J. A., & Moreno, J. (2019). Role of bacteria isolated from a plant waste-based compost producing bioactive substances in the control of bacterial spot syndrome caused by Xanthomonas campestris pv. vesicatoria. Biocatalysis and Agricultural Biotechnology, 20(101198), 101198. https://doi.org/10.1016/j.bcab.2019.101198
- Vílchez-Sánchez, P. (2024). Caracterización de compost y lixiviados recirculados procedentes de compostaje de restos vegetales a escala industrial. [Trabajo Fin de Máster, Universidad de Almería].

